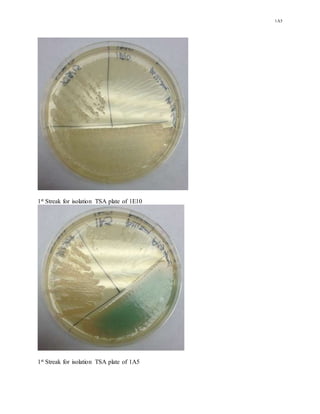
1A5
1st Streak for isolation TSA plate of 1E10
1st Streak for isolation TSA plate of 1A5
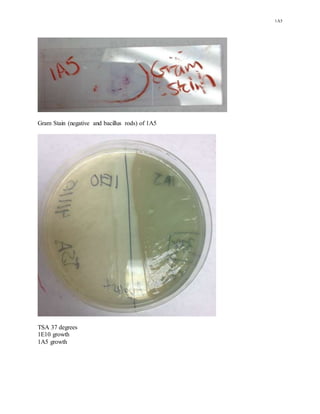
1A5
Gram Stain (negative and bacillus rods) of 1A5
TSA 37 degrees
1E10 growth
1A5 growth
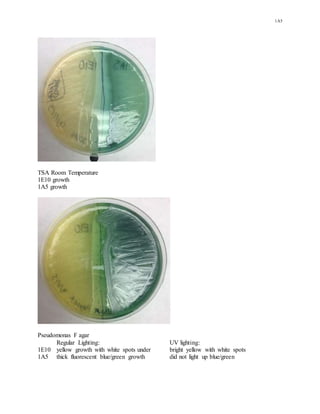
1A5
TSA Room Temperature
1E10 growth
1A5 growth
Pseudomonas F agar
Regular Lighting: UV lighting:
1E10 yellow growth with white spots under bright yellow with white spots
1A5 thick fluorescent blue/green growth did not light up blue/green
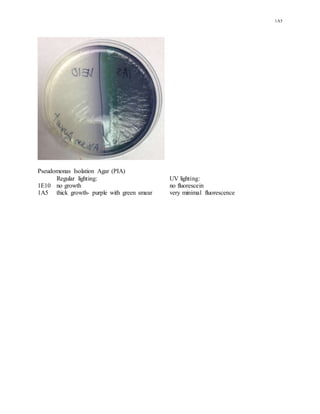
1A5
Pseudomonas Isolation Agar (PIA)
Regular lighting: UV lighting:
1E10 no growth no fluorescein
1A5 thick growth- purple with green smear very minimal fluorescence

The unknown microbe from sample 1A5 underwent a series of biochemical tests which identified it as Pseudomonas aeruginosa. A gram stain showed it was a gram negative bacillus that was motile and catalase positive. Further tests for cytochrome oxidase, growth on selective and differential media, and production of pyocyanin pigment eliminated other Pseudomonas species, confirming the microbe as P. aeruginosa.